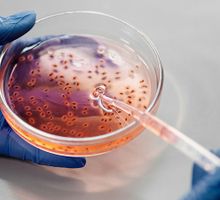
Puntos débiles en enterovirus abren la puerta a antivirales de amplio espectro

Cali, febrero 24 de 2026. Actualizado: martes, febrero 24, 2026 19:37
Refuerzan operativos
Buscan frenar reclutamiento de menores en Cauca

Al tiempo que rechazó el reclutamiento forzado de niños, niñas y adolescentes, por parte de grupos armados ilegales, el Ejército Nacional de Colombia intensificó el cerco militar en el suroccidente del país para frenar el reclutamiento y traslado de menores desde el Cauca hacia otras regiones.
El redoblamiento de las medidas se dio tras la denuncia sobre el caso de un niño de 14 años captado por las disidencias de las Farc y que fue denunciado por su familia
El Ejército recordó que esta práctica constituye una flagrante violación a los derechos humanos y al derecho internacional humanitario y que las operaciones continuarán de manera sostenida y coordinada para proteger a la niñez, neutralizar las estructuras armadas ilegales y consolidar la seguridad en el suroccidente del país.
El caso
Las medidas de reforzar el control se dieron luego de un caso denunciado en Caracol Radio en el que la familia de un menor, cuya madre y tía se internaron en zona controlada por el grupo armado que lo reclutó en el departamento del Guaviare para intentar rescatarlo.
El caso evidenció cómo estas estructuras utilizan engaños y promesas económicas para atraer a niños y adolescentes en zonas rurales.
Ya esta semana cuatro menores de edad fueron recuperados en zona rural de Jamundí. El comandante de la Tercera División, general Javier Africano, informó que más de 22 mil uniformados están desplegados en áreas estratégicas de Valle del Cauca, Cauca y Nariño, donde operan las disidencias de las Farc, el ELN y otras estructuras criminales.
Según explicó, las operaciones buscan cerrar los espacios que permiten a los grupos armados llegar a veredas y centros poblados donde convencen a menores de integrarse a sus filas.
El oficial afirmó que “tenemos desplegados más de 22 mil hombres en el suroccidente colombiano desarrollando operaciones militares en esas veredas y centros poblados donde estas estructuras llegan a engañar a nuestros niños”.
De acuerdo con el Ejército, en medio de los operativos se ha logrado recuperar menores que, tras la verificación con el Bienestar Familiar y la Policía de Infancia, fueron identificados como niños reclutados en el Cauca y trasladados a otros departamentos para fortalecer estructuras armadas.
Las autoridades aseguran que el aumento de presencia en zonas rurales busca cerrar la ruta de movilidad de los menores y afectar las retaguardias estratégicas de los grupos ilegales, evitando que continúe su utilización en el conflicto armado.